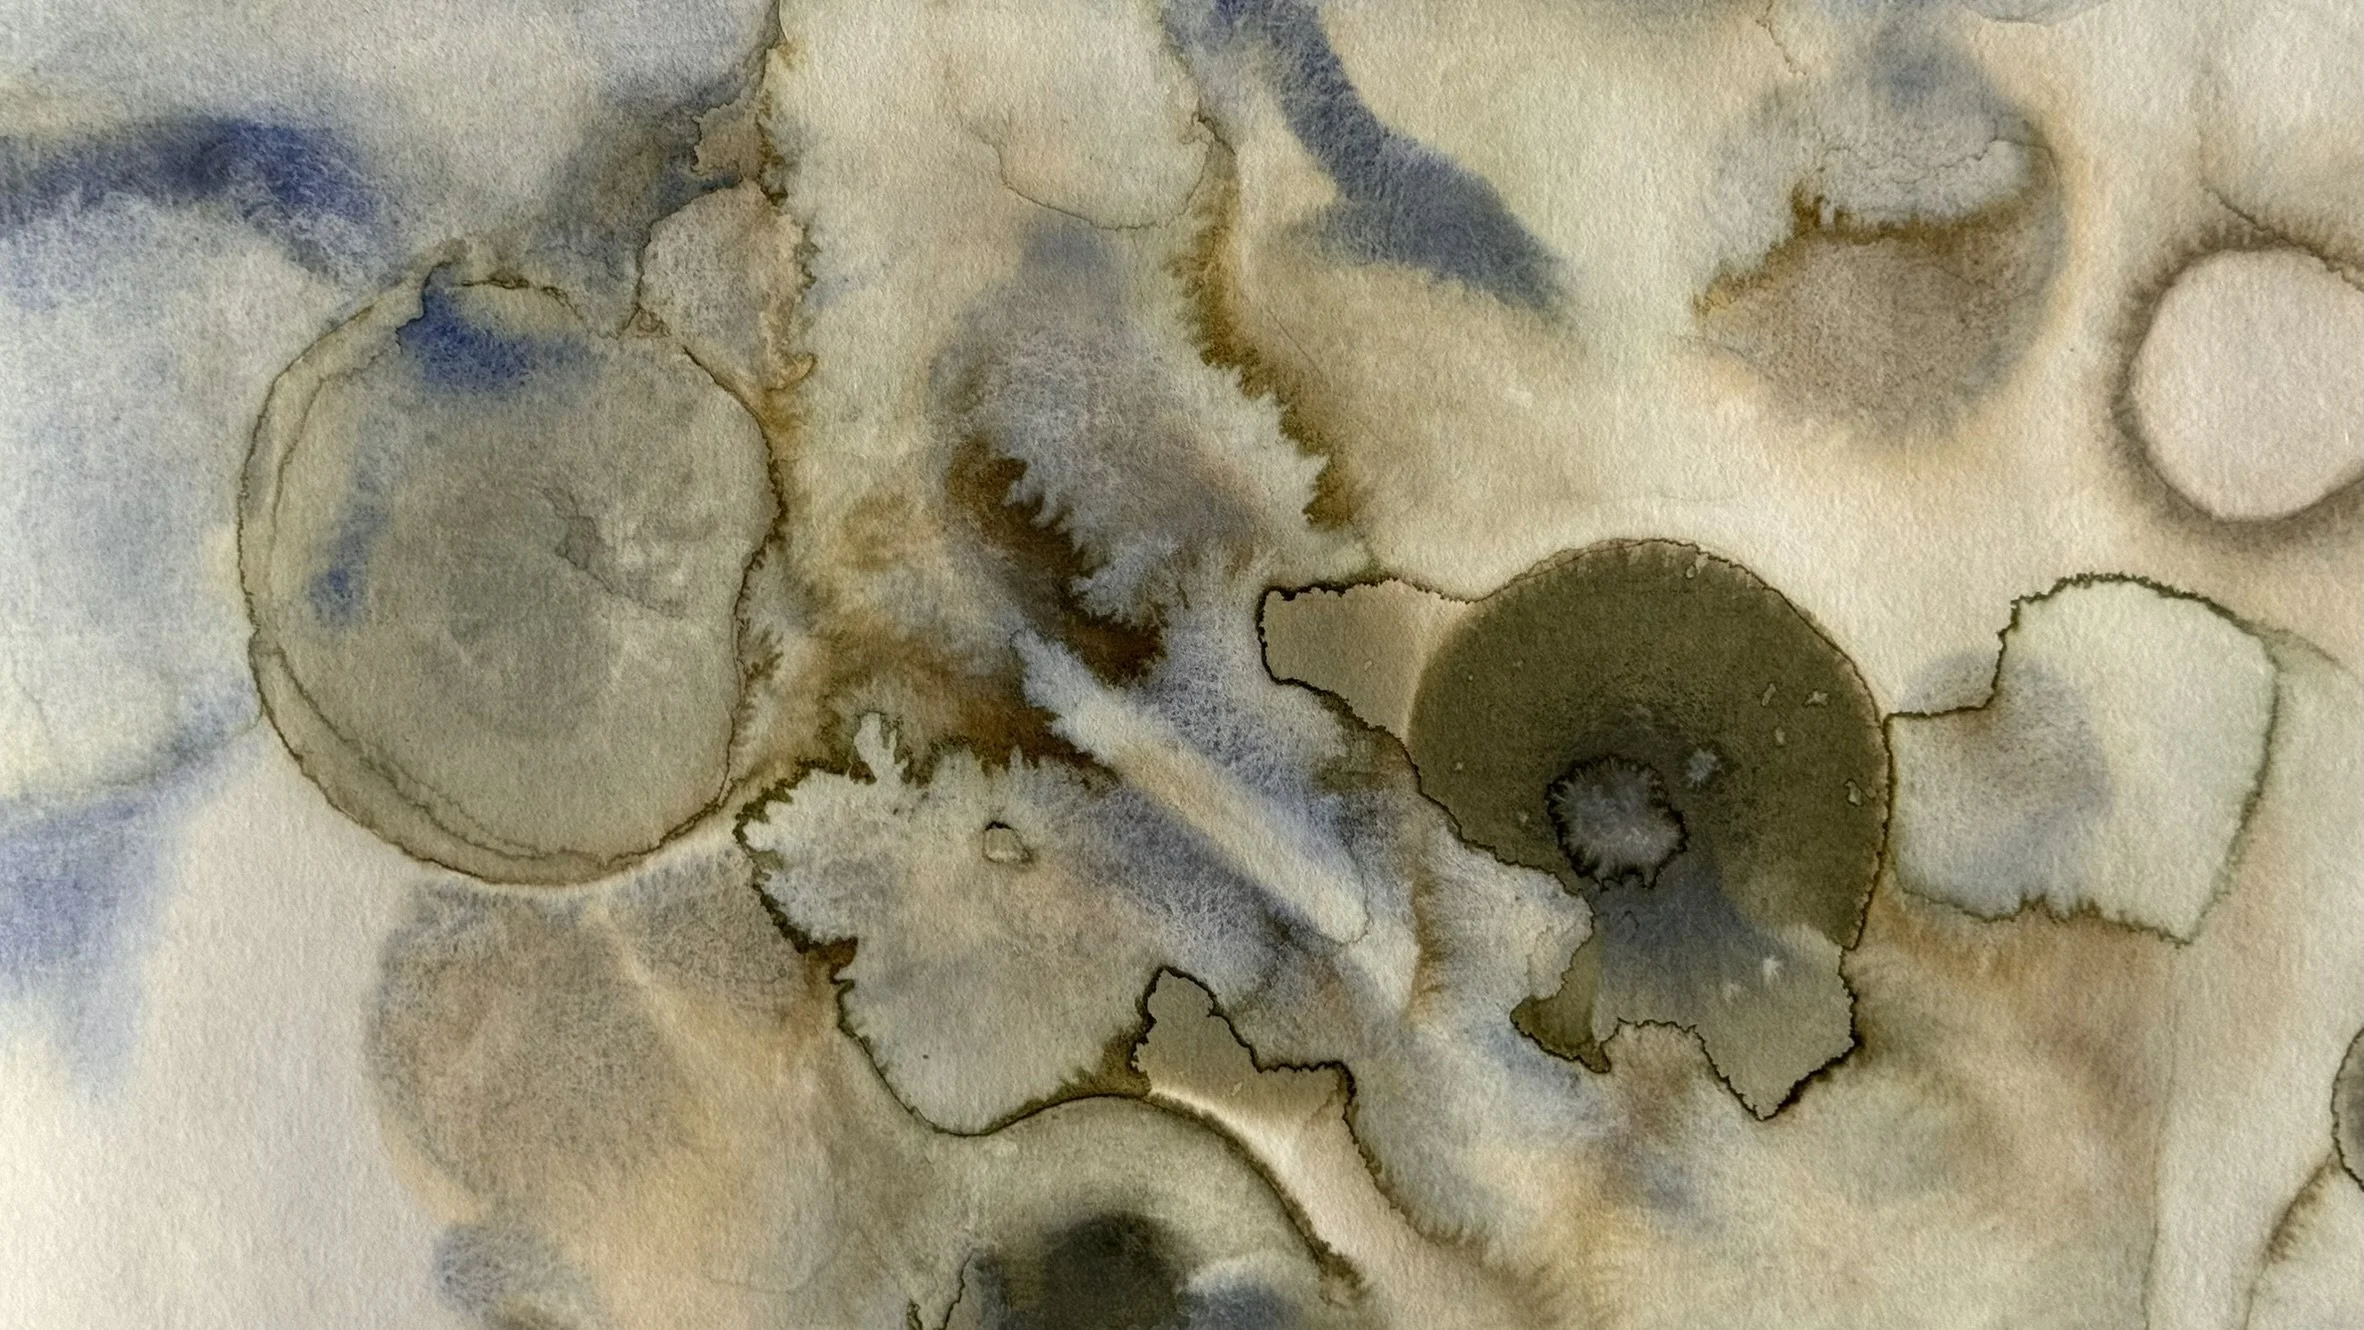

Célula, 2023. Aquarela sobre papel.
70 x 100 cm | 27,5 x 39,4 in
Inspirada no comportamento da água, não somente em rios e oceanos, mas também na atmosfera, nos micro-organismos, nos ventos e nas nuvens.
Materiais: Aquarelas profissionais Winsor and Newton, Ultramarine (Green Shade) (PB29) e Amarelo Ochre (PY43) em papel Hahnemühle, Cornwall Watercolour Board, 450g.
pormenores